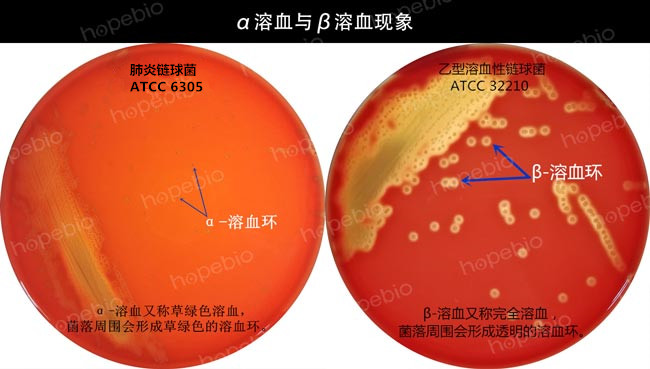
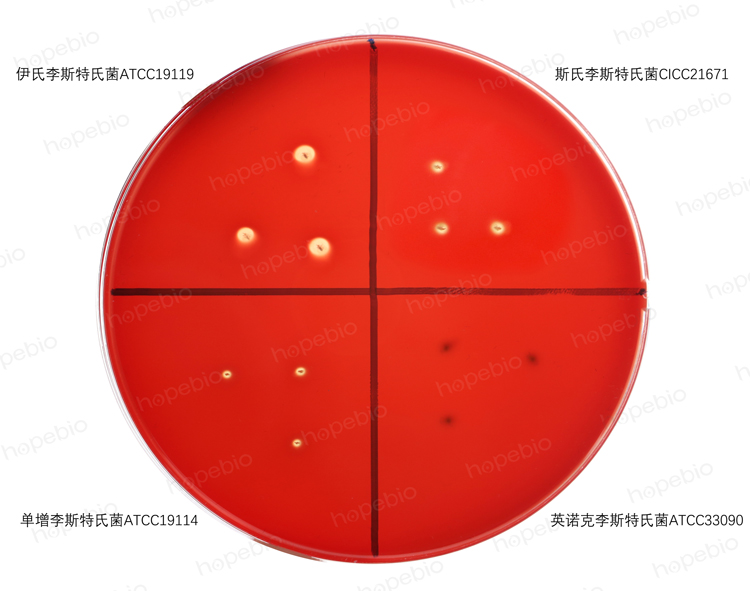
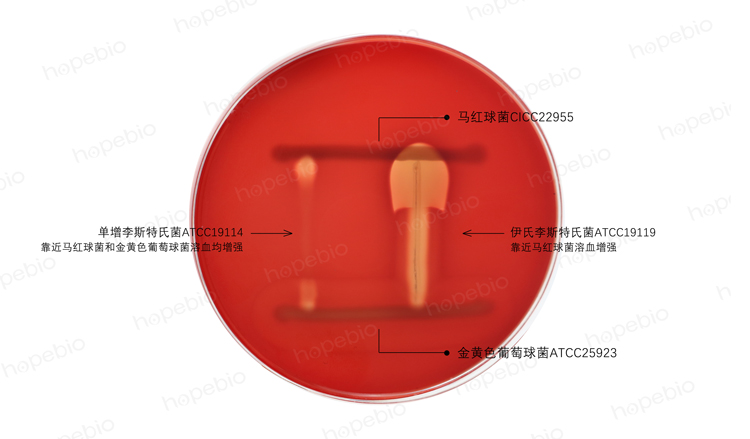
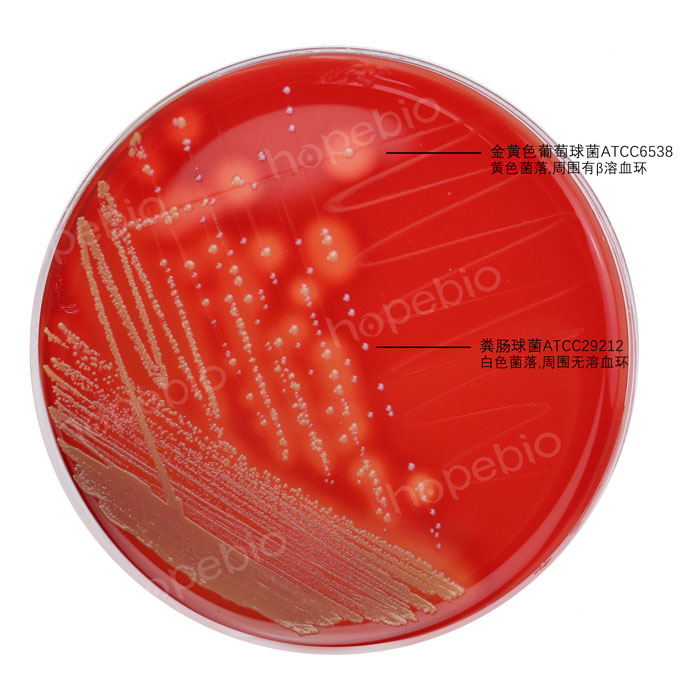

海博微信公众号
海博微信公众号
 海博天猫旗舰店
海博天猫旗舰店


 海博微信公众号
海博微信公众号
 海博天猫旗舰店
海博天猫旗舰店




一、简介
血琼脂平板培养基英文名称:Blood Agar,又叫做血平板、血平皿,是一种富含动物血液成分的琼脂平板,常用于微生物学实验中检测不同细菌对血液成分的反应;血琼脂平板通常由琼脂、肉汤、羊血或牛血等成分组成,其中的蛋白胨和牛肉粉主要提供细菌生长所需要的碳源、氮源、氨基酸及维生素;氯化钠维持培养基中的渗透压,琼脂用做凝固剂。脱纤维羊血一方面提供一些特殊的生长因子,另一方面用于观察溶血反应。
血琼脂平板可以用于分离和鉴定许多不同类型的微生物,如溶血性链球菌、李斯特氏菌、弧菌、金黄色葡萄球菌和蜡样芽孢杆菌等。
二、溶血现象
有关不同细菌在血琼脂平板上的溶血情况,可参考微生物特征图库。举例如下:
(1)肺炎链球菌的α溶血和乙型溶血性链球菌的β溶血,α溶血又称草绿色溶血,菌落周围会形成草绿色的溶血环,β溶血又称完全溶血,菌落周围会形成透明的溶血环。
(2)各种李斯特氏菌的溶血及协同溶血情况。伊氏李斯特氏菌、斯氏李斯特氏菌和单增李斯特氏菌呈现完全溶血现象,英诺克李斯特氏菌无溶血现象;伊氏李斯特氏菌靠近马红球菌溶血增强,单增李斯特氏菌靠近马红球菌和金黄色葡萄球菌落血均增强。

(3)我妻氏培养基上弧菌的溶血情况:副溶血性弧菌(ATCC 33847)菌落周围有透明的β溶血环,溶藻弧菌菌落周围无溶血环。

(4)金黄色葡萄球菌的溶血情况:金黄色葡萄球菌(ATCC 6538)菌落周围呈现完全溶血。
三、血琼脂基础的选择
实际工作中,可根据要求选择不同的血琼脂基础,如营养琼脂、豆粉琼脂或哥伦比亚琼脂(用于营养要求较高的细菌的培养及溶血试验)等,加蒸馏水溶解后高压灭菌。冷却至50℃~55℃,加入一定量的血液,缓慢混匀后倾注平板。
通常来说,如果只是想看一下溶血情况,只要用最基本的营养性琼脂,加入脱纤维羊血制成平板使用即可。但《GB 4789 食品安全国家标准 食品微生物学检验》系列标准中,针对不同细菌检验时,所规定的血琼脂的基础配方又有所不同:
(1)《GB 4789.10-2016 金黄色葡萄球菌检验》中,所用的血琼脂平板基础配方为:豆粉琼脂,添加的是脱纤维羊血或兔血。

豆粉琼脂的具体配方如下:(g/L)
|
牛心浸粉 |
15.0 |
|
氯化钠 |
5.0 |
|
豌豆浸粉 |
3.0 |
|
琼脂 |
15.0 |
|
pH值7.4-7.6 |
25℃ |
(2)《GB 4789.14-2014 蜡样芽孢杆菌检验》中,所用的血琼脂为:胰酪胨大豆羊血(TSSB)琼脂,添加的是脱纤维羊血。

(3)《GB 4789.30-2016 单核细胞增生李斯特氏菌检验》中,所用的血琼脂基础配方如下图,添加的是脱纤维羊血。

(4)《GB 4789.7-2013 副溶血性弧菌检验》中,做副溶血性弧菌神奈川试验所用的血琼脂为我妻氏血琼脂,配方如下图,添加的是新鲜洗涤的人或兔红细胞。

(5)《GB 4789.11-2014 β型溶血性链球菌检验》中,做β型溶血性链球菌分离所用的血琼脂为哥伦比亚CNA血琼脂,而进行鉴定所用的血琼脂为哥伦比亚血琼脂,各自的配方如下:


四、产品选择
由于各个标准中规定的血琼脂基础不同,在做血琼脂培养基时,一定要根据要求选择合适的血琼脂基础,现把我公司的相关产品信息列举如下,方便实验人员按需选用。
表1 针对不同标准的血琼脂培养基基础产品(注:点击产品名称或产品编号即可查看产品详情)
|
序号 |
标准编号 |
检验细菌 |
产品名称 |
产品编号 |
用途 |
|
1 |
GB4789.10-2016 |
金黄色葡萄球菌 |
用于分离营养要求较高的致病菌 |
||
|
2 |
GB4789.14-2014 |
蜡样芽孢杆菌 |
用于蜡样芽孢杆菌的溶血测试试验 |
||
|
3 |
GB4789.30-2016 |
单核增生李斯特氏菌 |
用于李斯特氏菌的溶血试验 |
||
|
4 |
GB4789.7-2013 |
副溶血性弧菌 |
用于副溶血性弧菌神奈川现象试验 |
||
|
5 |
GB4789.11-2014 |
β型溶血性链球菌 |
用于样品中革兰氏阳性菌的分离和鉴别培养 |
||
|
用于各种细菌的基础培养基 |
五、平板制备
培养基基础选定之后,根据需要加入不同形式的血液,即可制成血琼脂平板使用。若制作过程中有混合不均匀、有气泡或平板变黑等现象,可参考哥伦比亚血琼脂基础培养基的原理和使用方法所述方法尽量避免。本文就最关键的几点,再强调一下。
(1)由于血液不耐高温的特性,在血琼脂平板制作过程中,尤其要注意将培养基基础冷却至50℃左右,并且血液要平衡至30℃~40℃,再缓慢加入混合均匀。如果将血液直接从冰箱里拿出来马上加入培养基,由于温差较大,加入后很容易形成片状凝固。
(2)向培养基中添加血液时,缓慢放液,同时缓慢摇动三角瓶使相互混匀。放液太快容易形成片状凝固。摇动太剧烈会形成气泡,培养基粘度大气泡形成后很难消除。
(3)倾注培养基后,尽量放在水平地方冷却。如果摆放培养皿的台子不是平面,液体保持水平,而皿是斜的,最后造成培养基在某一直径上形成一边高一边低的现象。
(4)一定要留出充足的凝固时间,等培养基完全凝固后再收集平板。有时候看似凝固了,只是表面凝固,倒过来或移动后以会造成培养基平板坍塌或坑洼不平。
注:本文属海博生物原创,未经允许不得转载。
上一篇:鉴定类培养基的制备方法
下一篇:鉴定类培养基的检验方法
| 相关文章: | ||



